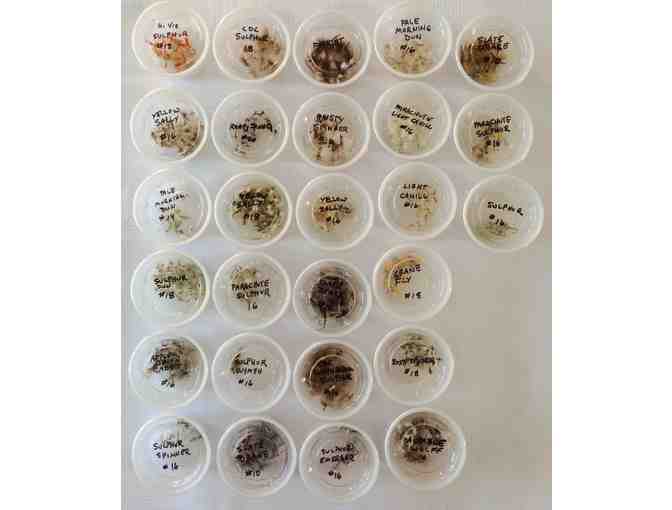

Lots of Dry Flies...Check out the List!
Item Number: 255
Time Left: CLOSED




Description
Hundreds of dry flies! Organized by pattern and size, this lot is valued at over $500. Everything you need to get you through dry fly season for the foreseeable future!
Hi Vis Sulphur #18, CDC Sulphur #18, Yellow Sally #16 and #18, Pale Morning Dun #16, Patriot, Parachute Light Cahill #16, Pale Morning Dun #14, Sulphur Dun #18, Rusty Spinner #14, #18 and #20, Parachute Sulphur #16, Slate Drake #10, #10 and #12, Ausable Wulff #10, Sulphur Spinner #16, Apple Green Caddis #16, CDC Comparadun Sulphur #16, Sulphur Nymph #16, Light Cahill #16, Sulphur Emerger #16, Sulphur #16 and Crane Fly #18.
Special Instructions
Shipping and handling additional - $15.00